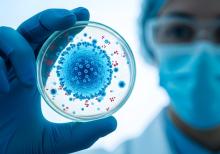
2 virus émergents pourraient constituer de prochaines menaces pour la santé publique : le virus de la grippe D et le coronavirus canin (Visuel Adobe Stock 1856053862) 2 virus émergents pourraient constituer de prochaines menaces pour la santé publique : le virus de la grippe D et le coronavirus canin (Visuel Adobe Stock 1856053862)

Vous recherchez une actualité
Actualités
Mode d'affichage :
-
MICROBIOTE INTESTINAL : Un régulateur clé entre croissance tumorale et immunité
Actualité publiée il y a 9 heures 29 minCICATRISATION : Des cellules clés déjà préparées à la reprogrammation épidermique
Actualité publiée il y a 9 heures 59 min
-
OBÉSITÉ : L’impact considérable de l’âge de la prise de poids
Actualité publiée il y a 10 heures 29 minSCHIZOPHRÉNIE : Premières zones cérébrales affectées, premier biomarqueur précoce
Actualité publiée il y a 10 heures 59 min
-
TUMEUR CÉRÉBRALE : Une nouvelle immunothérapie par gouttes nasales ?
Actualité publiée il y a 1 jour 9 heuresSANTÉ CÉRÉBROVASCULAIRE et DÉMENCE : Ces protéines nocives qui s’accumulent dans les vaisseaux
Actualité publiée il y a 1 jour 9 heures
-
PARKINSON : Découverte de marqueurs sanguins précoces
Actualité publiée il y a 1 jour 10 heuresMÉLANOME DESMOPLASTIQUE : L'immunothérapie préopératoire s'impose
Actualité publiée il y a 1 jour 10 heures
-
EXERCICE et SOMMEIL : 2 leviers majeurs pour éviter la démence
Actualité publiée il y a 2 jours 9 heuresESPÉRANCE de VIE : Vers un âge centenaire ?
Actualité publiée il y a 2 jours 9 heures
-
Le VAPING PASSIF : Ça existe !
Actualité publiée il y a 2 jours 10 heuresPANDÉMIE : 2 virus qui pourraient devenir une menace de santé publique
Actualité publiée il y a 3 jours 9 heures
-
EXCÈS d’ALCOOL : Son caractère occasionnel renforce ses effets
Actualité publiée il y a 3 jours 9 heuresSUBSTANCES PSYCHÉDÉLIQUES : Une étape vers leur utilisation clinique
Actualité publiée il y a 3 jours 10 heures
-
GLIOBLASTOME : Il affecte bien plus que le cerveau
Actualité publiée il y a 4 jours 9 heuresAGONISTES du GLP-1 : Le test qui prévoit l’ampleur de la perte de poids
Actualité publiée il y a 4 jours 9 heures
-
OBÉSITÉ : L’IMC, une métrique imparfaite mais plus précoce
Actualité publiée il y a 4 jours 10 heuresFIV : L’arrêt du développement embryonnaire plus souvent lié à l’âge maternel
Actualité publiée il y a 4 jours 10 heures
-
ACCOUCHEMENT : Quel mode de déclenchement privilégier ?
Actualité publiée il y a 5 jours 9 heuresNITRATES : Bénéfiques ou nocifs ? Tous ne se valent pas
Actualité publiée il y a 5 jours 9 heures
-
MÉNOPAUSE : Un peu de matière grise en moins ?
Actualité publiée il y a 5 jours 10 heuresSYNDROME de LEIGH : Vers un diagnostic plus précoce
Actualité publiée il y a 5 jours 10 heures
-
AXE INTESTIN-CERVEAU : Utiliser le microbiote pour traiter Parkinson
Actualité publiée il y a 6 jours 9 heuresQuels sont les différents types d’obésité ?
Actualité publiée il y a 6 jours 9 heures
-
PRATIQUE INFIRMIÈRE AVANCÉE : La mise en pratique clinique passe par les politiques de santé
Actualité publiée il y a 6 jours 9 heuresMUCUS, MUCINES : Ces anti-infectieux puissants et naturels
Actualité publiée il y a 6 jours 10 heures
-
GLYCANES : Ces sucres complexes qui façonnent le cerveau
Actualité publiée il y a 6 jours 10 heuresARTHROSE : Une injection de protéine qui répare le cartilage ?
Actualité publiée il y a 6 jours 12 heures
-
LYMPHŒDÈME SECONDAIRE : Du tissu bio-ingénierisé pour remplacer les ganglions
Actualité publiée il y a 1 semaine 9 heuresTRISOMIE 21 et dysfonctionnement hépatique
Actualité publiée il y a 1 semaine 9 heures
-
VIRUS du NIL OCCIDENTAL : Une menace émergente en Europe ?
Actualité publiée il y a 1 semaine 10 heuresSTÉATOSE HÉPATIQUE : Combiner exercice de résistance et aérobique
Actualité publiée il y a 1 semaine 10 heures
-
SOINS de PLAIE : Un lien certain entre solitude et inflammation
Actualité publiée il y a 1 semaine 1 jourTRAUMATIQUE ou TOXIQUE, le stress à l’enfance influence tous les aspects de la santé
Actualité publiée il y a 1 semaine 1 jour
Pages